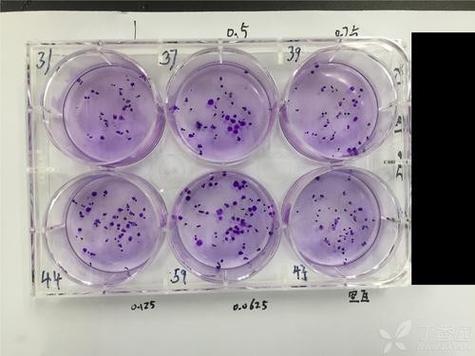
细胞上清代谢组学前处理关键步骤有哪些？-第3张图片-指南针培训网

核心原则与挑战
- 挑战1:高盐与培养基残留
细胞培养基(如DMEM、RPMI-1640)含有高浓度的盐(Na⁺, K⁺, PO₄³⁻)、氨基酸、维生素和缓冲剂(如HEPES),这些成分会严重干扰色谱分离和质谱检测,并抑制离子化效率。
- 挑战2:蛋白质干扰
培养基中含有大量血清蛋白(如胎牛血清),以及细胞分泌的蛋白质,这些蛋白质会污染色谱柱,堵塞质谱离子源,并导致代谢物吸附损失。

- 挑战3:代谢物多样性
代谢物种类繁多,极性、分子量、稳定性差异巨大,需要一种广谱的提取方法来捕获尽可能多的代谢物。
- 挑战4:动态范围广
代谢物浓度跨度极大,从纳摩尔级到毫摩尔级,前处理过程需要兼顾高丰度和低丰度代谢物的准确定量。
通用前处理流程(以LC-MS为例)
这是一个经典且通用的流程,可以根据具体分析目的进行微调。
步骤1:样品采集与预处理
-
收集上清:

- 在预定的时间点(如药物处理前后),小心吸取细胞培养上清。
- 关键: 动作要轻柔,避免吸起细胞沉淀。
- 快速操作: 为防止代谢物发生酶促或非酶促变化,整个过程应尽可能在冰上进行。
-
去除细胞碎片:
- 将收集的上清在 4°C 下,以 低速离心(通常为 500-2000 × g,5-10分钟)。
- 目的是去除因操作或细胞死亡脱落的细胞碎片和少量完整的细胞。
- 小心: 转速过高可能会沉淀一些小分子代谢物,导致结果偏低。
-
(可选)去除血清蛋白:
- 如果实验设计要求分析细胞自身分泌的代谢物,而非培养基中固有的代谢物,这一步至关重要。
- 常用方法:
- 超滤: 使用特定截留分子量(如3 kDa或10 kDa)的超滤管,在4°C下离心,这能有效去除大分子蛋白质,同时保留小分子代谢物,这是最常用且温和的方法。
- 沉淀法: 加入有机溶剂(如甲醇、乙腈)或酸(如三氯乙酸)使蛋白质沉淀,然后离心取上清,此法操作简单,但可能导致某些极性代谢物共沉淀而损失,且引入的酸或盐可能影响后续分析。
步骤2:代谢物提取(Quenching & Extraction)
这是前处理的核心,目的是“冻结”细胞代谢状态,并高效地提取代谢物。
-
代谢淬灭 - Quenching:
- 目的: 瞬间终止细胞内所有酶的活性,防止代谢物在收集和后续处理过程中继续变化。
- 方法:
- 冷甲醇淬灭: 将预冷至-40°C的甲醇溶液(如60%或80%甲醇水溶液)快速加入到等体积或一定比例的冰冷的细胞上清中,这是最常用的方法,能快速降温并使蛋白质变性。
- 冷溶剂淬灭: 使用预冷的乙腈、丙酮或甲醇-乙腈混合物。
- 操作: 加入淬灭溶剂后,需立即涡旋混匀,并在冰上孵育一段时间(如5-10分钟),确保淬灭完全。
-
代谢物提取 - Extraction:
- 目的: 从复杂的基质中最大限度地分离出目标代谢物。
- 常用溶剂体系(广谱提取):
- 甲醇/水/氯仿: 经典的Bligh-Dyer法,能有效提取极性(水相)和非极性(有机相)代谢物,适合脂质组学和广泛代谢物分析。
- 甲醇/乙腈/水: 这是目前代谢组学中最主流的提取体系,通常使用比例为40:40:20(甲醇:乙腈:水)或类似的组合,此体系蛋白沉淀效果好,代谢物回收率高,且与 reversed-phase LC-MS 兼容性好。
- 操作:
- 将淬灭后的样品涡旋混匀。
- 在4°C下进行 高速离心(通常为 12,000-16,000 × g,10-15分钟)。
- 离心后,样品会分层(如使用氯仿)或形成蛋白沉淀,小心吸取上清液(或特定层)至新的EP管中。
步骤3:样品浓缩与干燥
-
去除提取溶剂:
- 将上清液进行真空浓缩干燥,常用设备为 SpeedVac(真空离心浓缩仪)。
- 关键: 温度应设置在较低水平(如30-40°C),避免高温导致热不稳定的代谢物(如ATP、辅酶A等)降解。
-
复溶:
- 用与后续分析仪器兼容的溶剂(如初始流动相,如水/乙腈 = 95:5,含0.1%甲酸铵)重新溶解干燥的代谢物提取物。
- 关键:
- 溶剂选择: 必须保证代谢物完全溶解,避免沉淀。
- 体积一致: 所有样品的复溶体积必须严格一致,以保证浓度可比性。
- 涡旋与超声: 复溶后需充分涡旋,必要时可进行短时间超声助溶,确保样品均一。
步骤4:质控样品与内标
- 质控样品: 将等量的所有待测样品混合,制成一个“QC”(Quality Control)样品,在分析序列中,每隔5-10个样品插入一个QC,QC样品的色谱峰应高度重现,用于监控整个分析过程的稳定性和仪器状态。
- 内标: 在样品提取的早期阶段(如淬灭时或淬灭后)加入结构类似但自然界中不存在的稳定同位素标记的内标,内标可以校正样品前处理过程中的损失、基质效应和仪器信号漂移,是保证定量的准确性的关键,内标的选择应覆盖不同种类和极性的代谢物。
针对不同分析平台的方案调整
液相色谱-质谱联用
- 正/反相色谱:
- Reversed-Phase (C18柱): 适合分析中等非极性到非极性代谢物(如脂质、部分氨基酸、有机酸),常用提取溶剂为甲醇/乙腈/水。
- Hydrophilic Interaction Chromatography (HILIC柱): 适合分析强极性代谢物(如氨基酸、糖类、核苷酸、有机酸),常用提取溶剂为乙腈/甲醇。
- 质谱模式:
- 高分辨质谱: 如Q-TOF, Orbitrap,前处理要求更高,需特别注意盐分和基质效应,避免影响高分辨率的准确质量测定。
- 三重四极杆质谱: 用于靶向定量,对前处理的要求相对宽松,但基质效应会影响定量准确性,因此内标的使用至关重要。
气相色谱-质谱联用
- 特殊要求: GC-MS要求样品是挥发性或可衍生化的。
- 前处理调整:
- 提取: 通常使用单一有机溶剂(如甲醇)进行提取和沉淀。
- 干燥: 必须彻底干燥,去除所有水分。
- 衍生化: 这是GC-MS前处理最关键的一步,需要将极性代谢物(如有机酸、糖、氨基酸)通过甲硅烷化(如BSTFA)或酰化反应,增加其挥热稳定性和挥发性,衍生化过程需要严格控制时间和温度。
核磁共振
- 特殊要求: NMR对样品的盐分和pH极其敏感,高盐分会严重干扰信号,导致谱线增宽、基线抬高。
- 前处理调整:
- 除盐: 必须进行高效的除盐操作,常用方法包括:
- 固相萃取: 使用专用的混合型阳离子/阴离子交换柱。
- 超滤: 使用低截留分子量的超滤膜(如1 kDa)。
- 冻干-重溶: 是除盐和浓缩的经典方法,将样品冻干后,用重水(D₂O)和缓冲液(如磷酸盐缓冲液,pD 7.4)重新溶解,并加入化学位移参考物(如TSP或TSP-d4)。
- 除盐: 必须进行高效的除盐操作,常用方法包括:
关键注意事项与最佳实践
- 记录一切: 详细记录所有操作步骤、时间、温度、试剂批号、离心参数等,这是结果可重复性的基础。
- 使用冰水浴: 从样品收集到淬灭,全程在冰上操作,最大限度地保持代谢物原位状态。
- 避免冻融循环: 样品应分装后于-80°C保存,避免反复冻融导致代谢物降解。
- 设置生物学重复: 每个实验组至少设置3-5个生物学重复,以获得可靠的统计学结论。
- 做空白对照: 设置只加培养基、不加细胞的“空白培养基”对照,用于扣除培养基中原有代谢物的背景信号。
- 方法学验证: 如果进行靶向定量,需要对方法的线性范围、精密度、准确度、回收率、基质效应等进行验证。
总结流程图
graph TD
A[细胞培养] --> B{预定时间点};
B --> C[冰上小心吸取上清];
C --> D[4°C, 500-2000 g, 离心去除细胞碎片];
D --> E{是否去除血清蛋白?};
E -- 是 --> F[超滤/沉淀法];
E -- 否 --> G[直接进入下一步];
F --> G;
G --> H[加入预冷淬灭溶剂 (e.g., -40°C MeOH)];
H --> I[涡旋混匀, 冰上孵育];
I --> J[加入提取溶剂 (e.g., MeOH:ACN:H₂O)];
J --> K[涡旋混匀, 充分提取];
K --> L[4°C, 12,000-16,000 g, 高速离心];
L --> M[小心吸取上清];
M --> N{分析平台?};
N -- LC-MS --> O[真空干燥];
N -- GC-MS --> O;
N -- NMR --> P[高效除盐];
P --> Q[冻干];
O --> R[用初始流动相复溶];
Q --> R;
R --> S[涡旋/超声, 混匀];
S --> T[LC-MS/GC-MS/NMR 分析];
遵循以上规范化的流程,可以最大限度地保证细胞上清代谢组学数据的质量,为后续的生物信息学分析和生物学意义的解读奠定坚实的基础。
版权声明:除非特别标注,否则均为本站原创文章,转载时请以链接形式注明文章出处。